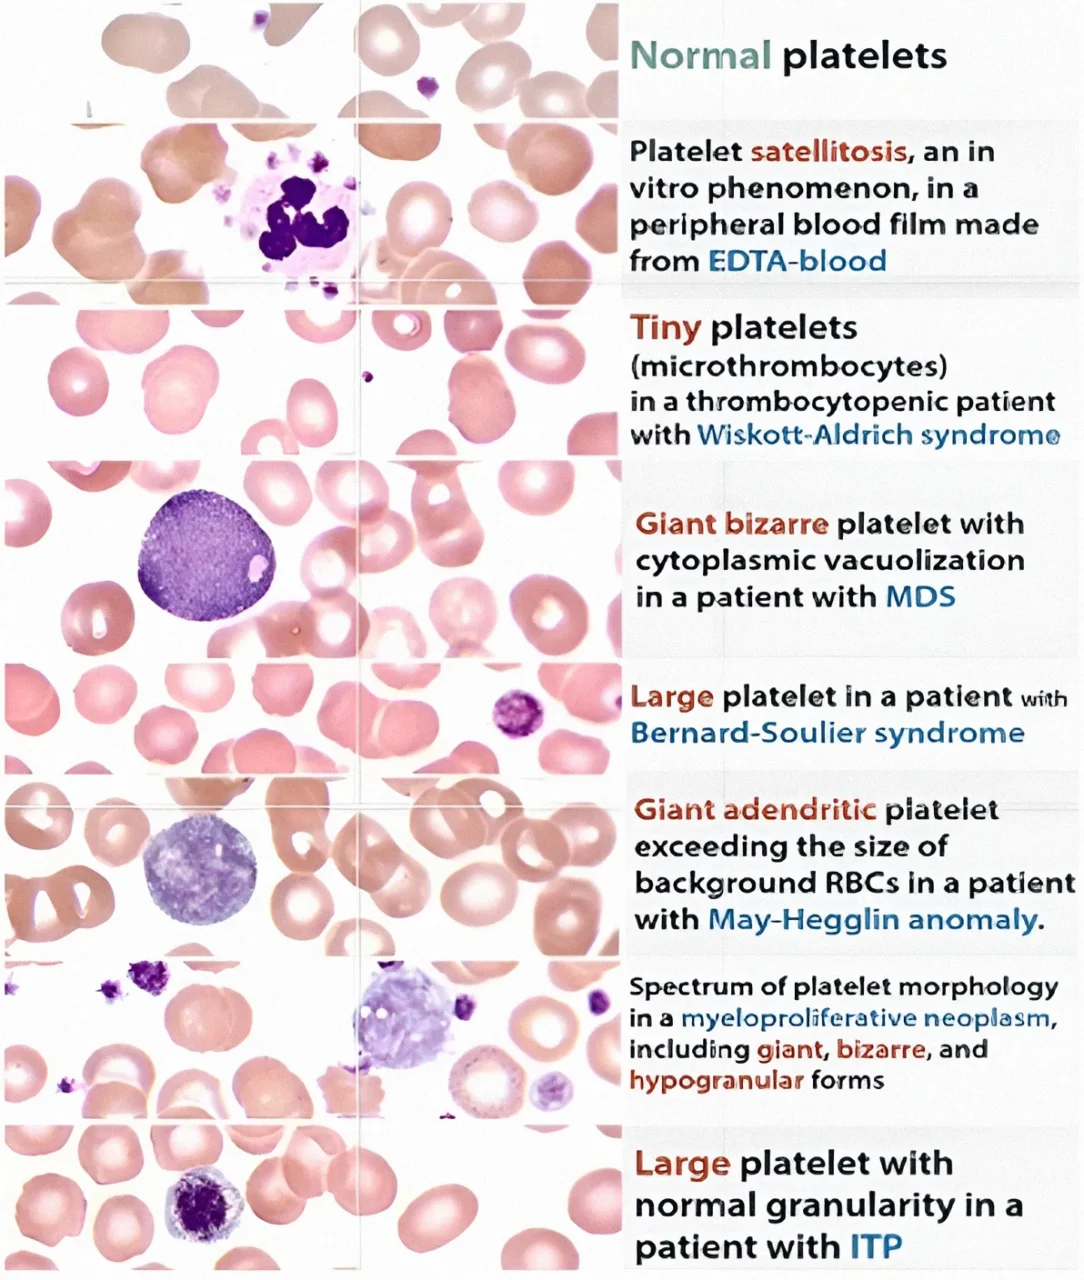
Peripheral Blood Smear (PBS) Under the Microscope: Bridging Morphology and Hematology

Peripheral Blood Smear (PBS) Under the Microscope: Bridging Morphology and Hematology
Peripheral blood smear (PBS) examination remains one of the most practical diagnostic tools in hematology. Direct visualization of blood cell morphology on stained films is irreplaceable, as automated hematology analyzers may overlook critical diagnostic features. Microscopic examination plays a key role in evaluating anemia, leukemia, infections, and platelet disorders. Let’s take a quick look at what can be seen on a PBS under the microscope and how it transforms analyzer numbers into more meaningful, reliable findings.
Common Pitfalls: What the Analyzer Might Miss
Automated analyzers are excellent screening tools, but they rely on predefined algorithms, physical parameters and lack detailed morphological insight, consequently, common pitfalls arise from:
- False results due to technical limitations
- Missed red blood cell morphology
- Misclassification of white blood cells
- Failure to detect platelet size abnormalities
- Missed infections detectable on smear
- Artifacts mistaken for pathology

When automated results are incomplete, discordant with the clinical context, or when an underlying hematologic disorder is suspected, PBS evaluation becomes essential prior to clinical decision-making.
How is a PBS prepared and examined?
Before morphology comes technique – as even minor preparation errors can mislead interpretation. Here are several key steps to consider.
1. Preparing the slide and making the smear – the most commonly used method is the wedge technique. A small drop of blood is placed near one end of a glass slide, and a second slide spreads it forward at a 30–45° angle. At this stage, dirty or greasy slides can create artifacts. Likewise, an incorrect angle or uneven spreading can produce tails, waves, or films that are too thick or too thin.
2. Proper drying – the smear should be air-dried quickly at room temperature before staining. Slow drying, excess humidity, or exposure to heat may produce artefacts such as echinocytes and distorted leukocytes.
3. Staining process – a buffered Romanowsky method is used (Wright, Wright-Giemsa, or Leishman), which allows cellular components to be distinguished by both color and structure. Stain precipitate may appear as dark granules mimicking parasites or inclusions, while water artefact-often caused by hypotonic rinse solutions or excess moisture can produce vacuolated (“moth-eaten”) red cells.
4. Timing and sample handling – prolonged exposure to EDTA may cause platelet clumping and swelling of white blood cells, while cold agglutinins can lead to red cell clumping and spuriously abnormal indices.

5. Microscopic examination – the blood film is first examined under low magnification (×200) to assess overall smear quality, while also screening for unusually large or immature cells, the feathered edge is carefully reviewed for platelet clumps. Medium magnification (×400) allows assessment of abnormal cells, red cell aggregation or rouleaux, background bluish staining suggestive of paraproteinemia, and the presence of parasites. Finally, the optimal area of the smear is examined at high magnification (×1000, oil immersion) to systematically assess the size, shape, and morphology of the major cell lineages (Ali, 2025, Kaushansky et al., 2025).
What Red Cells Can Tell Us?
Normal red blood cells are biconcave discs measuring approximately the diameter of a small lymphocyte nucleus. Hemoglobin is distributed peripherally, leaving a central pallor that normally occupies less than one-half of the cell diameter. Cells of normal size and hemoglobin content (color) are normocytic and normochromic.
Macrocytes and microcytes are red cells larger or smaller than normal, and their presence consistent with the measured MCV suggests certain diagnostic possibilities (for instance, microcytosis in iron deficiency or thalassemia, and macrocytosis in B12/B9 deficiency, liver disease, hypothyroidism, alcohol use, certain drugs).
Increased central pallor (hypochromia) is associated with diminished hemoglobin synthesis. A predominance of hypochromic microcytic cells is found in iron deficiency, thalassemia, hereditary sideroblastic anemia, in some patients with the anemia of chronic disorders and with lead intoxication.

Early (“shift” or “stress”) reticulocytes (those with the most residual RNA) appear in stained films as large, slightly bluish cells, referred to as polychromatophilic cells. Polychromasia signals a reticulocyte response, nucleated RBCs imply marrow stress, severe hemolysis, or hypoxia.
Rouleaux formation is a phrase denoting the stacking of erythrocytes. It is normal in the thick part of the film, but when found in the optimal viewing portion, suggest a pathologic increase in immunoglobulin, particularly IgM-macroglobulinemia. Occasionally, high concentrations of IgA or IgG in patients with myeloma may also produce rouleaux.
Anisocytosis is the term that describes variation in erythrocyte size, and is the morphologic correlate of the RDW. Unusual variation in shape is called poikilocytosis. PBS of healthy individuals reveals small numbers of poikilocytes (< 2%). In the assessment of the significance of poikilocytosis, one must identify the predominant abnormal morphologic form.

Schistocytes are fragmented erythrocytes appearing in a variety of morphologic forms (small triangular erythrocytes, helmet cells, normal-size erythrocytes with pointed surface projections/”horn cells”).The combination of schistocytes and thrombocytopenia raises suspicion for microangiopathic hemolysis. Bite cells are round erythrocytes with a single surface defect, formed when splenic macrophages remove denatured hemoglobin caused by oxidative stress (as seen in G6PD deficiency).
Morphologic identification of inclusion bodies can be clinically helpful. Howell-Jolly bodies (purple spheres within the cytoplasm) are nuclear remnants seen in hyposplenism or megaloblastic change. Heinz bodies and HbH inclusions indicate unstable hemoglobins or oxidative injury.
Basophilic stippling of erythrocytes-seen in dyserythropoiesis, thalassemia, and lead poisoning-consists of numerous very small coarse blue granules within the cytoplasm. When these stippled particles represent iron granules (demonstrable by the Prussian blue stain), they are termed Pappenheimer bodies. Malaria parasites may also appear as cytoplasmic inclusion bodies within erythrocytes.

Platelets in Focus
In a normally stained blood film, platelets appear as small blue or colorless bodies with red-purple granules, and may vary in shape, ranging from round to elongated, cigar-shaped forms. In a PBS, platelet morphology can be assessed and the platelet count estimated directly. The diagnosis of thrombocytopenia and conditions associated with thrombocytopenia is aided by the presence of giant platelets, platelet clumping, or a low platelet count.
A blood smear helps distinguish true thrombocytopenia from EDTA-induced pseudothrombocytopenia, which occurs due to platelet clumping or satellitism (adherence of platelets to neutrophils). Platelet clumps may also indicate a problem with blood sample collection, particularly when faulty venipuncture causes platelet activation before proper mixing with anticoagulant.
An increased proportion of large or giant platelets is typically seen in conditions with enhanced platelet turnover or abnormal production, such as immune-mediated thrombocytopenia, disseminated intravascular coagulation, myeloproliferative disorders (especially myelofibrosis), megaloblastic anemias, the Bernard-Soulier syndrome, and the May-Heggelin anomaly. Microthrombocytes are characteristic of Wiskott-Aldrich syndrome, while hypogranular platelets are commonly observed in myeloproliferative disorders. In contrast, platelet size is usually normal in hypersplenic states.
Patterns in White Blood Cell Morphology
The WBCs normally found in blood are mature neutrophils, lymphocytes, and monocytes, with smaller numbers of eosinophils and basophils. Neutrophils are medium-sized cells with a nucleus divided into 3-5 lobes connected by thin chromatin strands, giving them their characteristic segmented appearance.
In fully mature forms, the chromatin appears dense and coarsely clumped, staining a deep purple and reflecting a terminal stage of differentiation. Left shift is commonly associated with inflammatory toxic changes and may also occur in acute hemorrhage or hemolysis, stress responses, myeloproliferative neoplasms (very typical of CML), and recovery following bone marrow suppression.

In systemic inflammation, neutrophil granules may enlarge and darken, appearing dark blue-black, a feature known as toxic granulation, which can be mistaken for basophil granules. Coarse dark granules may also be seen in neutrophils in mucopolysaccharidoses, with large azurophilic granules in some lymphocytes and monocytes. In Chédiak-Higashi syndrome, neutrophils display huge misshapen granules, while lymphocytes show giant azurophilic granules.
Neutrophils may show pale blue cytoplasmic inclusions, such as Döhle bodies in infections, inflammation, during pregnancy, after cytotoxic chemotherapy and reflect accelerated neutrophil maturation with residual endoplasmic reticulum retained from the promyelocyte stage. Similar irregular inclusions are seen in MYH9-related disorders (May-Hegglin anomaly), while neutrophil function remains normal.
Hypersegmented neutrophils usually are an important clue to the presence of vitamin B12 or B9 deficiency but are occasionally found in patients with myelodysplasia or myeloproliferative disorders. Pelger-Hüet cells, bilobed or monolobed neutrophils, can be hereditary with normal function or acquired, indicating neutrophilic dysplasia (pseudo Pelger-Huet). Vacuoles can form in the nucleus and cytoplasm of monocytes and neutrophils, during prolonged storage in EDTA-anticoagulated blood. In films prepared without anticoagulant, neutrophilic vacuoles may indicate sepsis.

Eosinophils are slightly larger than neutrophils and are recognized by their bright orange-red granules. In contrast, basophils have a faint, usually less segmented nucleus and larger, deeply basophilic granules. Abnormalities in their number or morphology may suggest allergic, inflammatory, infectious or myeloproliferative disorders.
Monocytes are the largest normal blood cells, with a round, kidney-shaped, or lobulated nucleus. Their gray cytoplasm, resulting from fine pink granules over a blue RNA-containing background, helps distinguish monocytes from reactive lymphocytes.
The small lymphocyte is the most common lymphocyte type in normal blood. Large granular lymphocytes typically represent cytotoxic T or NK cells. Reactive lymphocytes, seen in viral infections, are distinguished from neoplastic cells by a lower nuclear-to-cytoplasmic ratio and more condensed chromatin ( Kaushansky et al., 2025, NCBI Bookshelf).
Can PBS Detect Blood Cancer?
Although not definitive on its own, a PBS can offer an early window into underlying blood cancers. Subtle abnormalities, ranging from circulating blasts to dysplastic white cells or unusual lymphoid populations – may be the first indication of a malignant process.
Under normal conditions, blasts are absent from the bloodstream, and their appearance, even in small numbers, immediately raises concern. On a PBS, they tend to stand out: larger than most circulating cells, with a dominant nucleus, delicate chromatin, and often visible nucleoli that give the cell a “soft,” open appearance.
The PBS helps distinguish acute from chronic leukemia (for instance, a left shift in CML). Another classic example is chronic lymphocytic leukemia (CLL), where small lymphocytes show dense, clumped (“soccer-ball”) chromatin. These are frequently accompanied by smudge cells – fragile lymphocytes that rupture during slide preparation, leaving behind smeared nuclear remnants.
These are some common microscopic findings, with many mixed cell morphology cases not included. A PBS can therefore help triage patients who may require further bone marrow examination, cytogenetic studies, or molecular testing.
How Is PBS Being Reshaped in the Digital Era?
PBS examination is undergoing a clear transition toward digital and AI-driven solutions. Modern digital microscopy systems can now scan entire slides at high resolution, generating whole-slide images that can be archived and accessed instantly for teaching, quality assurance, or remote consultation. This has enabled the growth of telehaematology, allowing specialists to review cases from anywhere.
According to Xing Y et al. (2023), AI-assisted digital morphology systems have been shown to increase diagnostic accuracy by 7.4% for normal leukocyte classification and up to 15.2% for abnormal cells. In some studies, blast detection sensitivity has been reported at 96-99%, with specificity above 90-95%. For platelet analysis, AI-assisted systems have demonstrated detection accuracies of around 92-96%, including improved recognition of platelet clumps and giant platelets.
According to Lazaro JB et al. (2025), deep learning models in anemia classification have reported accuracies of ~90-97% in distinguishing morphological patterns. Importantly, while manual microscopy typically evaluates 200-400 cells per smear, AI-based systems can analyze tens of thousands to over one million cells per slide while reducing inter-observer variability by 20-30% through improved consistency and standardization.

However, the success of these technologies remains tightly linked to pre-analytical and analytical quality, as artefacts can mislead both human observers and algorithms. Implementation of digital PBS systems requires robust local validation against manual differentials across stains, scanners, magnifications, and patient populations.
Standardization of color calibration, imaging parameters, along with LIS integration and secure image archiving (DICOM-compatible), is essential for reliable workflows. Laboratories must also address automation bias, participate in external quality assessment, and perform periodic revalidation after software updates.
Maintaining a “human-in-the-loop” approach is equally important, as expert oversight is essential for interpreting findings in clinical context, including unexpected features and therapy-related changes, ensuring that AI augments professional judgment.
Written by Susanna Mikayelyan, MD
Stay Informed with Hemostasis Today.
-
Jun 1, 2026, 18:51Francesco Giurazza: New Publication on Glubran-2 in Acute Bleeding Patients with Coagulopathies
-
Jun 1, 2026, 18:50Donald Arnold is the Recipient of the Roberts Award – ISTH
-
Jun 1, 2026, 18:49Amirreza Jabbaripour Sarmadian: My First Paper as Corresponding Author on Upper Extremity DVT Following COVID-19 Vaccination
-
Jun 1, 2026, 18:49James P. Crowley: How Combining Vitamin D analogs with Chemotherapy Impacts Survival Outcomes
-
Jun 1, 2026, 18:42Debojyoti Chakraborty: Small But Meaningful Steps Toward A Gene Editing Trial For Sickle Cell Disease In India
-
Jun 1, 2026, 17:14Tiffany Gacel: What an Incredible Day With NBCA and The Red Bus Tour at Memorial at Gulfport?
-
Jun 1, 2026, 17:12Marie-Claire Kofi: Poster Highlights the Process of Establishing the Sickle Cell Transitions Policy Lab
-
Jun 1, 2026, 17:00Azusa Nagao: Organizing the Symposium on Women and Bleeding Disorders at JSTH Annual Meeting
-
Jun 1, 2026, 16:57Kuljeet Kaur: Approach to Anemia – More Than Just a Low Hemoglobin

